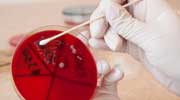
Content Dam Diq Online Articles 2015 02 Bacteria Enterococcus Faecalis Dreamstime Article Thumbnail
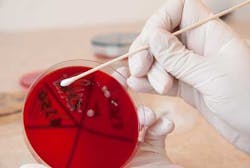

Research update: Virus shown to be effective in preventing infection following root canal procedures
Viruses are being used as hired killers for a new purpose, according to an article from Medical News Today.
Bacteriophages, also called phages, are viruses that infect bacteria. Over time, these phages have evolved into highly developed killers. At one time phages were used largely in creating antibiotics. Now, researchers have isolated a phage called EFDG1, but what makes this most interesting is that they isolated it from sewage in Jerusalem.
Read the study abstract here.
References
Khalifa L, et al. Targeting Enterococcus faecalis biofilm using phage therapy. AEM[published online]. February 6 2015. doi:10.1128/AEM.00096-15
ADDITIONAL READING ...
Infective endocarditis and antibiotic prophylaxis: Is there an association?
A periodontist's protocols to avoid dental implant complications: Part 1